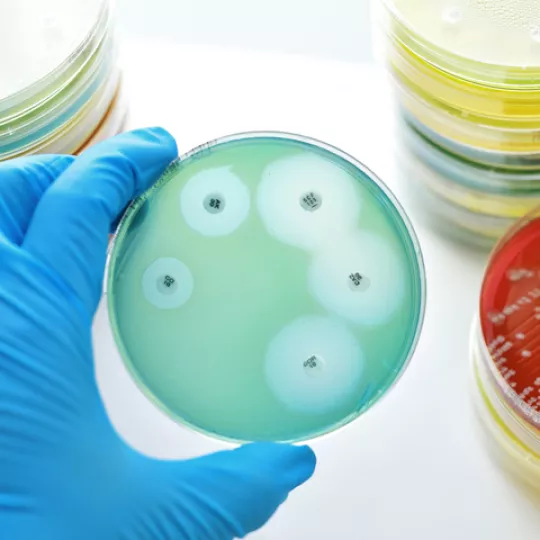

Analysis of antimicrobial consumption and resistance ('JIACRA' reports)
The European Medicines Agency (EMA) works closely with the European Food Safety Authority (EFSA) and the European Centre for Disease Prevention and Control (ECDC) to analyse the potential relationship between the consumption of antimicrobials by humans and animals and the occurrence of antimicrobial resistance.
VeterinaryAntimicrobial resistance